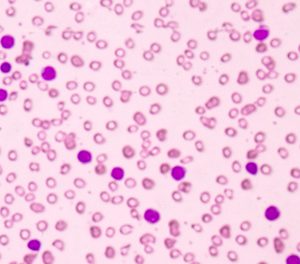

First patient treated in Phase I UCART19 trial in paediatric B-ALL
21 June 2016 | By Victoria White, Digital Content Producer
The Phase I study will evaluate the ability of UCART19 to induce molecular remission in paediatric patients with relapsed or refractory CD19 positive B-ALL...